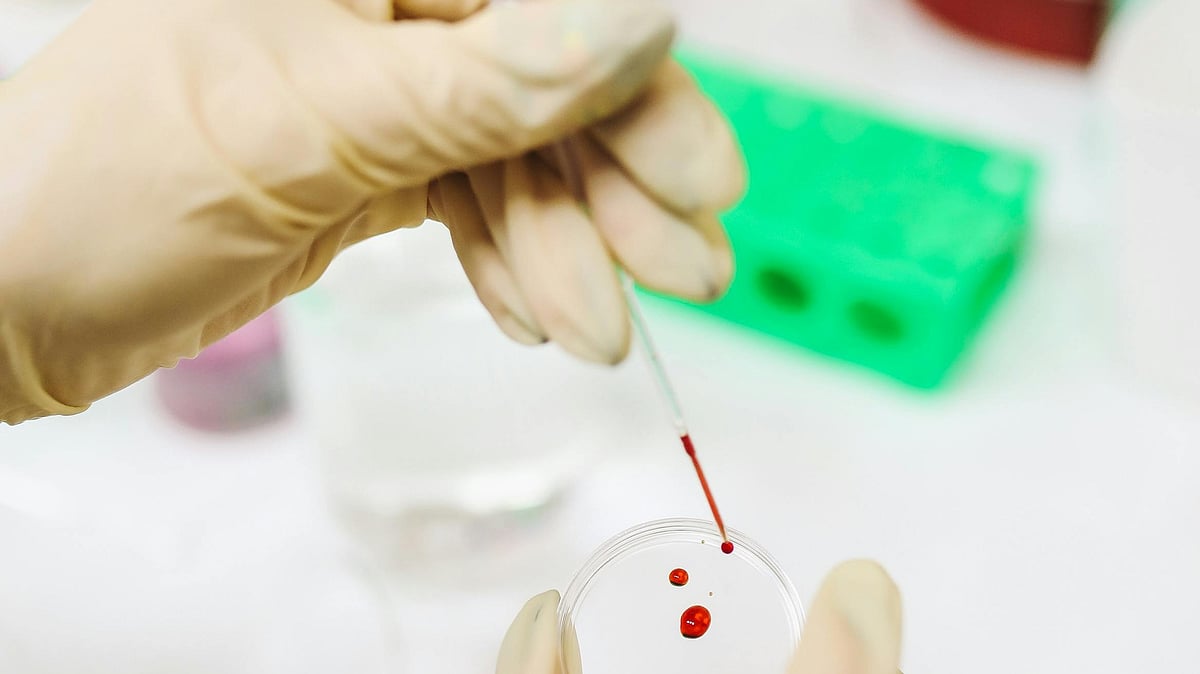
ছবি: পেক্সেলস

রক্তের চর্বির পরিমাণ জানতে লিপিড প্রোফাইল পরীক্ষা করা হয়ে থাকে। বর্তমানে এটি একটি রুটিন টেস্ট হয়ে গেছে। ৪০ বছর বয়সের পর সবারই এই পরীক্ষা করা উচিত। কারণ, লিপিড প্রোফাইল বেশি থাকলে এ থেকে হৃদ্রোগ, হার্ট অ্যাটাক, স্ট্রোক ইত্যাদি হওয়ার আশঙ্কা থাকে।
লিপিড প্রোফাইল পরীক্ষা করার আগে কিছু প্রস্তুতি আছে।
সাধারণত ৯-১২ ঘণ্টা না খেয়ে লিপিড প্রোফাইল টেস্ট করা হয়। রক্তে কোলেস্টেরল শুধু না, লিপিড প্রোফাইলে আরও দেখা হয় এইচডিএল (হাই-ডেনসিটি লিপোপ্রোটিন), এলডিএল (লো-ডেনসিটি লিপোপ্রোটিন) এবং ট্রাই গ্লিসারাইড। এইচডিএল হলো ভালো কোলেস্টেরল, যা বেশি থাকা ভালো। এইচডিএল হার্ট অ্যাটাক ও স্ট্রোক প্রতিরোধ করে। বাকিগুলো স্বাভাবিক মাত্রার চেয়ে বেশি থাকলে নানা রোগের ঝুঁকি বাড়ে।
লিপিড প্রোফাইলের ধরন বুঝে ডাক্তার ওষুধ দিয়ে থাকেন। ডায়াবেটিস আছে কি না, রক্তচাপ কেমন, হার্ট ডিজিজ আছে কি না, রোগীর নিজের বা তাঁর কোনো নিকটাত্মীয় কম বয়সে স্ট্রোক বা হার্ট অ্যাটাকে আক্রান্ত হয়ে থাকলে কোলেস্টেরল কমানোর ওষুধ দেওয়া হয়।
রক্তে চর্বির পরিমাণ বেশি থাকলে জীবনযাত্রায় কিছু পরিবর্তন আনতে সচেষ্ট হওয়া উচিত। নয়তো ধমনিতে এই ক্ষতিকর চর্বি জমে নানা রোগ সৃষ্টি করতে পারে।
নিয়মিত শারীরিক পরিশ্রম, ব্যায়াম, ওজন কমানো, তৈলাক্ত খাবার (ঘি, মাখন, গরুর মাংস, কলিজা, মগজ, অস্থিমজ্জা, চামড়া, চিংড়ি, পাঙাশ ও কাতল মাছ) পরিহার করা উচিত।
খেতে হবে ফাইবারযুক্ত খাবার—শাকসবজি, শিম, দুগ্ধজাত খাবার, আখরোট, তিসি, চিয়া বীজ।
রান্নায় তেলের পরিমাণ কমান। যেকোনো তেল অতিরিক্ত ব্যবহার ক্ষতিকর। কোলেস্টেরলমুক্ত তেল বলে আসলে কিছু নেই।
ওমেগা ৩ ফ্যাটি অ্যাসিড পাওয়া যায় এমন মাছ (সার্ডিন, টুনা) খাওয়া, বীজ (তিসি, আখরোট, চিয়া), ক্যানোলা, তিসির তেল, সয়াবিন তেল ওমেগা ৩ ফ্যাটি অ্যাসিডসমৃদ্ধ।
ধূমপান ও অ্যালকোহল বর্জনীয়।
ডা. রোজানা রউফ: সহযোগী কনসালট্যান্ট, মেডিসিন বিভাগ, স্কয়ার হাসপাতাল লিমিটেড, ঢাকা